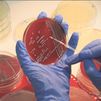
En España fallecen al año 4.000 personas por resistencias a los antibióticos

El Ministerio de Sanidad revisará los envases de los antibióticos y fomentará el uso de los de menor tamaño posible para cubrir los tratamientos completos y evitar sobrantes. Y es que su mala utilización provoca bacterias resistentes a estos medicamentos.
El objetivo es frenar las infecciones cada vez más frecuentes causadas por bacterias resistentes a los antibióticos.
El nuevo plan de Sanidad los revisará para tratar que se ajusten mejor a los tratamientos y evitar así excedentes de antibióticos que se quedan en casa y que algunos después usan sin necesidad.
También se busca que los pacientes no abandonen los tratamientos a la mitad cuando ya se encuentran bien. Ahí es donde se genera el riesgo de provocar resistencias bacterianas.
Cerca de 4.000 personas mueren cada año en España por la resistencia bacteriana. Un problema global que no sólo afecta a la salud humana sino también a la animal y que podría afectar, en el futuro, a la economía mundial.